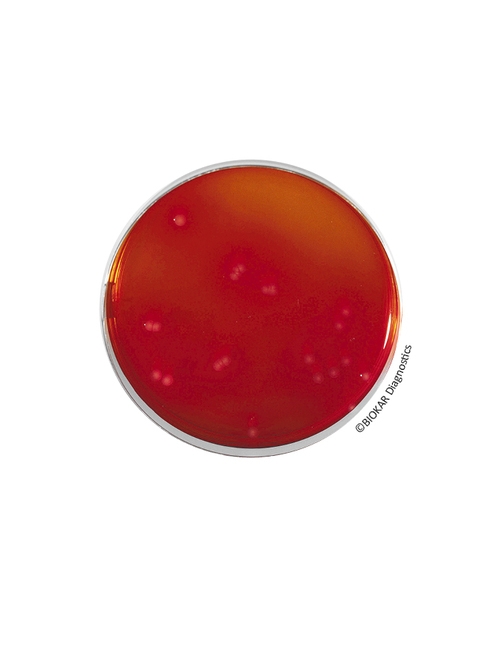
img

Brilliant Green Agar (EDEL & KAMPELMACHER)
Brilliant Green Agar (EDEL & KAMPELMACHER)
Brilliant Green Agar (Edel & Kampelmacher), süt ve süt ürünlerinde Salmonella spp. türlerini izole etmek için kullanılan seçici bir besiyeridir. Bu besiyeri, Salmonella spp. tespiti için çeşitli normalize edilmiş yöntemler bağlamında ikinci bir izolasyon ortamı olarak da kullanılabilir.
Ürün Adı: Brıllıant Green Agar (EDEL & KAMPELMACHER)
Ürün Kodu: BK091HA
Miktar: 500 g
